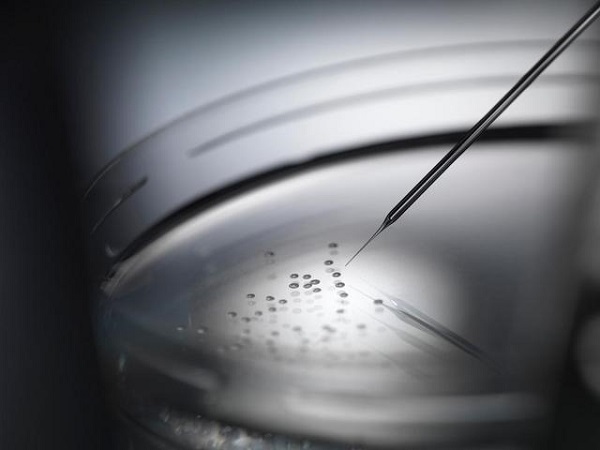

-
上海三代试管婴儿(甜丁APP科普:第二代试管婴儿成功率高吗?)
现如今随着医疗技术的不断提升,不孕不育患者人数的增加,临床经验的丰富和积累,全国范围内的试管婴儿成功率都在不断进步不断提高。通常,如果男女双方都无疾病,正常情况下每个月的怀孕可能性也只有10%。如果男女双方有疾病...
-
成都供卵价格(直观分析试管婴儿成功率高吗)
试管婴儿的成功率高吗?一直是想要试管人群所关心的问题。虽然第三代试管婴儿技术是目前治疗不孕不育有效的方法,而且被众人选择,但试管的成功率并不是百分之百的,和很多因素都有关。如下:...
-
上海单身女人试管多少钱(原创 夫妻久别重逢,男人怎么判断,女人有没有“偷吃”?)
原标题:夫妻久别重逢,男人怎么判断,女人有没有“偷吃”? 导言: 夫妻之间的感情是需要经营和维护的,但有时候,由于工作、生活等原因,夫妻可能需要长时间分离。这种分离会让人们感到孤独和寂寞,也可能会导致夫妻之间的感情疏远。当夫妻久别重逢时,男人如何判断女人是否“偷吃”?这是...
-
上海借卵试管婴儿(做一个试管婴儿要在医院住多久?租房子会不会更方便?万科金色梦想——中信湘雅周边财富原始投资不容错过)
看到验孕棒上出现的两条红线 林女士愣了足足三分钟 才想起来要给老公报喜 从开始进行试管婴儿治疗到现在 她已经在长沙待了整整半年 5月初 她辞掉了工作 从汕头来到长沙 在中信湘雅医院附近租了个公寓 专心调养身体...
-
成都助孕电话(首批幸运儿已有人怀孕!第二批免费试管婴儿治疗名额正在报名中)
好消息!首批获得免费试管婴儿治疗的10名幸运儿已经有一名成功怀孕,目前第二批10个免费治疗名额正在火热报名中,有需要的你赶快行动起来! 为关爱不孕症人群,纪念广东省首例试管婴儿在广医三院诞生30周年,时值广医三院建院120周年之际,广州医科大学附属第三医院在今年5月12日的母亲节当...
-
成都三代试管多少钱(女人有这几个特征,说明皮肤白嫩凝眸紧致,名门泽佳教你怎么判断)
越是上了年纪越觉得人比人真是气死人!在同龄人当中,明明都是三十多岁或四十多岁的年龄,为什么有些人看起来就是更年轻,皮肤也更好。 在生活中我们总是以...
-
成都供卵中心(精诚年会 引八方客源慕名而来)
2018年1月14日,广州精诚生殖服务中心总公司年会在广州花园酒店隆重召开,来自长沙、重庆、汕头等分公司的员工代表们欢聚一堂,共同见证了这场视觉盛宴。现场还有两百多名外界嘉宾应邀出席并道贺精诚公司海外第三方生殖辅助技术为三百多名家庭圆了生儿育女梦,赢得现场观众热烈的掌声和...
-
上海供卵中介(怎么判断一个女人是不是情场高手?)
1、情场老司机只要给她钱,她什么都可以做,可以说毫无底线,她们和任何男人都没有真感情,只是表面上玩一下,等男人不再给她提供金钱,她就会立马抽身,寻找下一个目标。...
-
上海助孕中介哪里好(做试管有必要在医院附近租房吗?)
结合个人经历经验分享一下做试管在医院附近租房的利弊:好的方面: 1.离医院近,节约体力,做检查排队方便。比如重庆妇幼医院门口对面一栋楼几乎都是给做试管的出租房,距离医院几十米。促排后期要连续每天做B超,每天都要很早过去排队,去得早,做的早。我每次从家里出发坐轻轨过去要半个多小时,天...
-
上海借卵生子(怎么判断一个男人值不值得嫁?)
“巨婴”是近年来流行的一个词。与我们前两个故事中提到的“焦虑型人格”和“回避型人格”不同,“巨婴”尚未成为一个严谨的心理学概念,但也值得探讨。 因为一方面,这一概念已被公众认可和接...